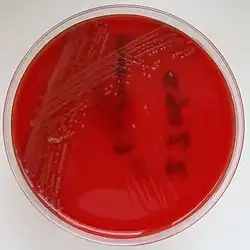

Listeriose
| Listeriosis | |
|---|---|
 | |
| Listeria monocytogenes | |
| Especialidade | infecciologia, ginecologia e obstetrícia, neonatologia, medicina fetal |
| Classificação e recursos externos | |
| CID-11 | 1C1A |
| CID-10 | A32 |
| CID-9 | 027.0 |
| DiseasesDB | 7503 |
| MedlinePlus | 001380 |
| eMedicine | med/1312 ped/1319 |
| MeSH | D008088 |
Listeriose é uma infecção bacteriana provocada pela Listeria monocytogenes,[1] que é um bacilo móvel gram positivo. Outros listerias causam infecções apenas em animais.
Causa

Listeria monocytogenes é comumente encontrado no solo e na água. Os animais domésticos e selvagens podem carregar a bactéria sem parecerem doentes. A bactéria pode ser encontrada em alimentos, tais como:[2]
- Carnes mal cozidas (como carne mal passada, carnes finas e cachorros-quentes);
- Leite não pasteurizado, bem como seus derivados (especialmente queijos macios);
- Frutos do mar defumados;
- Frutos e vegetais irrigados com água contaminada ou fertilizado com fezes de animais infectados.
A bactéria morre se o alimento é bem cozido. Vegetais e frutas devem ser bem lavados. Pessoas saudáveis raramente ficam doentes. Pode crescer e espalhar dentro da geladeira a outros alimentos.[3]
O período de incubação varia de 3 a 70 dias. Pode ser encontrado em patês de origem animal, cachorro-quente, carnes finas, queijos frescos Feta, Brie, Camemberte e outros alimentos prontos para consumo. Pode ser evitado cozinhando bem os alimentos.[4]
Grupos vulneráveis
Afeta principalmente recém nascidos, grávidas, em idosos e pessoas com imunidade baixa. Pode passar de mãe para o feto através da placenta e causar aborto, nascimento prematuro ou resultar natimorto.[5]
Sinais e sintomas
Em pessoas saudáveis que consomem alimentos contaminados causa apenas uma infecção alimentar leve poucos dias após o consumo do alimento infectado. Os sintomas gastrointestinais incluem:[6]
Por outro lado, se a infecção atinge o cérebro ou meninges causa:[2]
- Dor de cabeça;
- Torcicolo;
- Confusão mental;
- Tontura;
- Sensibilidade a luz;
- Convulsões.
Durante a gravidez, além dos sintomas já listados também causa:[6]
- Perda de apetite;
- Irritabilidade;
- Vômitos;
- Fatiga;
- Parto prematuro;
- Infecção do feto e natimorto;
- Outras formas de infecção[7]
- Infecção do coração (endocardite)
- Infecção do líquido cerebrospinal e meninges (meningite)
- Infecção pulmonar (pneumonia)
- Infecção sanguínea (septicemia)
- Infecção ocular (conjuntivite)
- Infecção da pele (dermatite)
- Infecção de tecido conjuntivo purulenta (abcesso)
Epidemiologia
Ocorreram vários surtos nos EUA e Canadá entre 1998 e 2011. Nos EUA, cerca de 1600 casos são diagnosticados e resultaram e causam 260 mortes por ano. Quando uma mulher grávida é infectada a mortalidade do feto é de 20 a 30%.[8] Na Europa a incidência é de 2 a 5 casos para cada milhão de habitantes.[9]
Apesar de casos de meningites e abortos por listeriose já terem sido identificados no Brasil, a doença segue sub-diagnosticada e sub-notificada. Em estudo de Porto Alegre de 10 placentas de aborto e partos prematuros 50% foram por listeriose. Parece ser mais comum no Sul e Sudeste, por seus hábitos alimentares, ou pode ser apenas mais diagnosticado nessas regiões e não notificado nas outras.[10]
Tratamento
Caso o paciente seja vulnerável é tratado com antibióticos, como ampicilina ou trimetoprim com sulfametoxazol, sendo que as doses e combinações de medicamentos variam dependendo do local afetado. Pessoas saudáveis com problemas gástricos não precisam de tratamento antibiótico, os sintomas desaparecem em poucas semanas.[7] Em caso de endocardite, pode-se administrar-se uma penicilina associada com tobramicina. Conjuntivites podem ser tratadas com eritromicina.A penicilina geralmente cura a listeriose. Se a infecção tiver afectado as válvulas cardíacas, pode também administrar-se um segundo antibiótico, como a tobramicina. As infecções oculares também podem ser tratadas com eritromicina oral.[11]
Referências
- ↑ Ryan KJ; Ray CG (editors) (2004). Sherris Medical Microbiology 4ª ed. [S.l.]: McGraw Hill. ISBN 0-8385-8529-9
- ↑ a b CDC (1 de março de 2018). «Frequently Asked Questions about Listeria». Centers for Disease Control and Prevention (em inglês). Consultado em 26 de maio de 2022
- ↑ «Listeria infection (listeriosis) - Symptoms and causes». Mayo Clinic (em inglês). Consultado em 26 de maio de 2022
- ↑ Affairs (ASPA), Assistant Secretary for Public (12 de abril de 2019). «Bacteria and Viruses». FoodSafety.gov (em inglês). Consultado em 26 de maio de 2022
- ↑ Hof H (1996). Listeria Monocytogenes in: Baron's Medical Microbiology (Baron S et al, eds.) 4ª ed. [S.l.]: Univ of Texas Medical Branch. (via NCBI Bookshelf) ISBN 0-9631172-1-1
- ↑ a b «Listeria infection (listeriosis) - Symptoms and causes». Mayo Clinic (em inglês). Consultado em 26 de maio de 2022
- ↑ a b «Listeriosis: MedlinePlus enciclopedia médica». medlineplus.gov (em espanhol). Consultado em 26 de maio de 2022
- ↑ «Information for Health Professionals and Laboratories | Listeria | CDC». www.cdc.gov (em inglês). 30 de março de 2021. Consultado em 26 de maio de 2022
- ↑ Smittskyddsinstitutet –Statistik för listeriainfektion
- ↑ CRUZ, C.D.; MARTINEZ, M.B.; DESTRO, M.T. Listeria monocytogenes: an infectious agent scarcely known in Brazil. Alim.Nutr., v. 19, n. 2, p. 195-206, abr./jun. 2008.
- ↑ «Manual MSD Versão Saúde para a Família». Manual MSD Versão Saúde para a Família. Consultado em 26 de maio de 2022